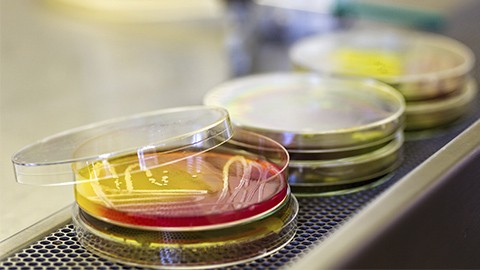

La Universidad de Barcelona, la Universidad Autónoma de Barcelona y la Universidad Politécnica de Catalunya ponen en marcha la segunda edición del Programa "De la ciencia al mercado", un curso formativo para fomentar la transferencia universidad-empresa.
El Programa se desarrollará del próximo 15 de octubre al 22 de noviembre y consta de 120 horas de formación sobre transferencia de conocimiento y creación de empresas. Además, cada proyecto disfrutará de entre 5 y 10 horas de tutoría individualizada con profesionales expertos del sector.
Está dirigido a estudiantes y personas tituladas de máster o doctorado de cualquier universidad que hayan desarrollado una tecnología diferencial, con ganas de poner en valor su tesis o tesina y convertirla en empresa y/o de formar parte de un equipo emprendedor.
La inscripciones al programa, que es gratuito, ya están abiertas y se pueden hacer a través de este enlace: http://www.cienciamercat.cat/index.php/inscripcio/
"De la ciencia al mercado" cuenta con el apoyo del Departamento de Empresa y Conocimiento de la Generalitat de Catalunya y la cofinanciación del Fondo Social Europeo, a través del Programa Catalunya Emprèn.
Más información Página web del Programa